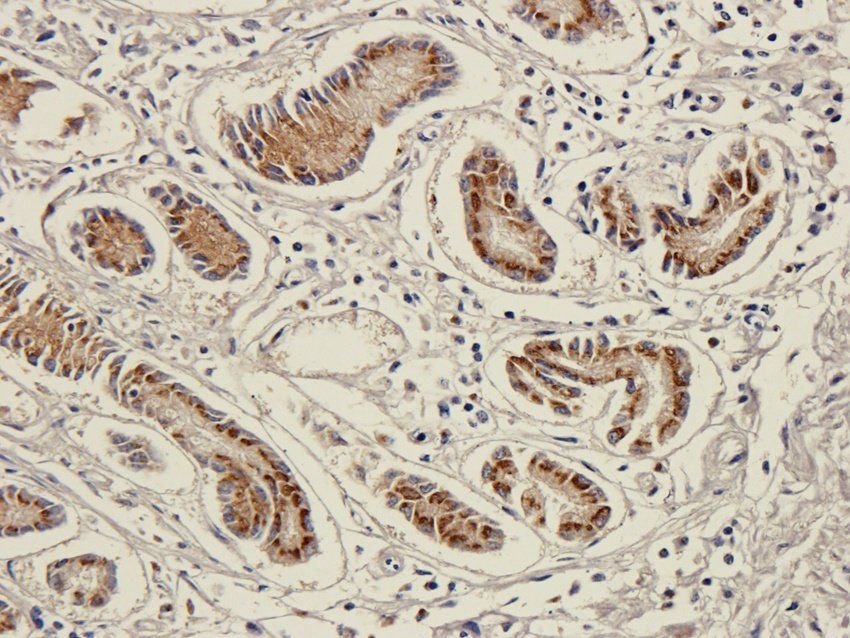
ICAM1 antibody

You have no items in your shopping cart.
Search results for: 'ICAM-1 (CD54)'
Rat
0.32-20ng/mL
0.19 ng/mL
96 T, 48 THuman
0.32-20ng/mL
0.19 ng/mL
96 T, 48 TRat
0.31-20ng/mL
0.19 ng/mL
96 T, 48 THuman
0.31-20ng/mL
0.16 ng/mL
48 T, 96 T- ICAM1 antibody [orb101441]Featured

ICC, IF, IHC-P, WB
Goat, Guinea pig, Human, Mouse, Rat
Bovine, Porcine
Rabbit
Polyclonal
Unconjugated
100 μg - ICAM1/CD54 Mouse Monoclonal Antibody [orb500866]Featured

IF, IHC-Fr, IHC-P
Human
Mouse
Monoclonal
Unconjugated
200 μg, 200 μl, 50 μl, 100 μl - Mouse ICAM-1 [orb2992854]
SDS-PAGE: Greater than 95% as determined by reducing SDS-PAGE. (QC verified)
Predicted: 51.1 KDa. Observed: 68-127 KDa, reducing conditions
1 mg, 500 μg, 50 μg, 10 μg